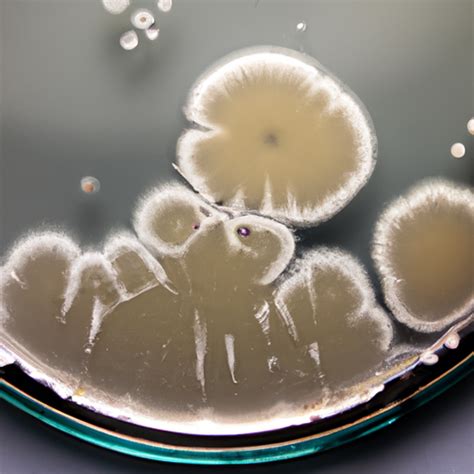

Zombie News: Updates, Outbreaks, And Survival Tips
Zombie News: Updates, Outbreaks, and Survival Tips
Hey guys, let’s dive into the fascinating, and sometimes terrifying, world of zombies! We’re talking about the latest zombie news , from potential outbreaks (thankfully, fictional…for now!) to the best survival tips in case the undead ever decide to rise. This article is your one-stop shop for all things zombie, covering everything from the newest zombie movies and zombie games to the science (and pseudo-science) behind the walking dead . So, grab your virtual bat and let’s get started. We’ll be exploring the different facets of the zombie apocalypse , giving you the lowdown on what’s hot in the zombie-verse, and maybe even prepping you for the (highly unlikely) event of a real-life undead invasion. Remember, knowledge is power, and knowing your zombies is half the battle! We will be looking at everything from the origins of the undead trope to the ways in which society might respond to a zombie pandemic . Get ready for a deep dive into the guts, (or what’s left of them), of all things zombie!
Table of Contents
- The Latest Zombie Outbreak News
- Notable Zombie Games and Movies
- Understanding the Zombie Phenomenon: More Than Just the Undead
- The Science (or Lack Thereof) Behind the Walking Dead
- Zombie Survival Tips: How to Prepare for the Apocalypse
- Essential Survival Kit Checklist
- The Future of Zombies: What’s Next?
The Latest Zombie Outbreak News
Alright, so while there aren’t any actual flesh-eating hordes roaming the streets (phew!), there’s always plenty of buzz in the zombie world. We’re constantly bombarded with news about new zombie movies promising fresh takes on the classic undead theme. This year has seen some amazing additions to the world of the walking dead . From big-budget blockbusters to indie flicks, the creative minds behind these films are always looking for new ways to scare us. Think of it as a constant evolution, with each new release adding a unique flavor to the zombie genre. We’re talking about everything from fast zombies to slow zombies, smart zombies to dumb zombies, and everything in between! And the great thing about the zombie genre is that it provides a perfect backdrop for social commentary. Filmmakers often use zombies to explore themes like societal collapse, the breakdown of community, and the struggle for survival in a post-apocalyptic world. Some of the best zombie movies aren’t just about gore and guts; they delve into the human condition. They force us to ask ourselves: What would we do? Who would we become? And who would we trust? If you’re a fan of zombie games , you’re in luck too. The gaming industry is still churning out tons of zombie-themed titles, offering a variety of experiences. This includes everything from first-person shooters where you battle hordes of zombies to strategy games where you must build a base and manage resources in a zombie-infested world. These games allow us to experience the thrill of the zombie apocalypse firsthand, offering a safe and controlled environment to test our survival skills. They let us imagine how we might react under pressure, and they provide a sense of camaraderie as we team up with friends to fight the undead. So, whether you are playing alone or with friends, these games let you immerse yourself fully into the world of the undead . From open-world exploration to intense survival scenarios, there’s a zombie game out there for everyone. The beauty of the zombie genre is its versatility. It can be adapted to any format.
Notable Zombie Games and Movies
Let’s get into some specifics, shall we? This year has been particularly interesting with some amazing games and movies that should be added to your list.
Movie Spotlight:
-
[Insert Movie Title and Details Here]
.
- Why You Should Watch It: This movie offers a fresh take on the classic zombie formula, with amazing visuals and a compelling storyline. (Remember to replace this with an actual movie name, details, and your recommendation.)
Gaming Corner:
-
[Insert Game Title and Details Here]
.
- Why You Should Play It: This game features innovative gameplay mechanics and a deep crafting system, offering a unique survival experience. (Remember to replace this with an actual game name, details, and your recommendation.)
These are just a couple of examples. But the zombie news cycle never stops! You can always find new games and movies to fill your time with the undead .
Understanding the Zombie Phenomenon: More Than Just the Undead
Okay, let’s talk about the cultural impact of zombies. It’s not just about gore and jump scares, guys. Zombies have become a huge part of our pop culture. They reflect our fears, our anxieties, and even our hopes for the future. They’re a blank canvas onto which we project our anxieties about pandemics, social unrest, and the breakdown of society. They show us what happens when our institutions fail, when trust crumbles, and when we’re left to fend for ourselves. And as the world changes, so do our zombies. They have constantly been evolving to reflect our current worries. The slow, shambling zombies of the past have given way to fast-moving, intelligent creatures. And the zombie outbreak has become a metaphor for everything from climate change to political polarization. Think about it: zombies are a constant presence in our movies, TV shows, and video games. They’re even in our books, comics, and art. The fact that we keep coming back to this theme, time and time again, says a lot about us. Zombie movies and zombie games give us a chance to explore those fears in a safe environment. We can confront our anxieties about death, disease, and societal collapse, and maybe even find some hope in the process. The sheer longevity of the zombie genre is a testament to its enduring power. It has its roots in folklore and literature, reaching back centuries. But it really took off in the modern era with films like Night of the Living Dead . And since then, it’s never really gone away. Each generation has found new ways to interpret and adapt the zombie mythos, adding their own unique perspectives to the mix. It’s a genre that refuses to die, constantly reinventing itself and staying relevant in a world that’s always changing.
The Science (or Lack Thereof) Behind the Walking Dead
While we don’t have actual real-life zombies (thank goodness!), it’s fun to speculate about the science behind a zombie outbreak . What would it take? Could it happen? If it happened, how would it spread? Let’s be clear: the science of zombies is firmly rooted in the realm of fiction. The idea of reanimating the dead is something that, as far as we know, is beyond our current scientific capabilities. However, that doesn’t stop us from having a little fun and exploring the possibilities. Many zombie movies and zombie games offer different explanations for the origin of the undead . Some involve viruses, some involve radiation, and some even involve ancient curses. The key is to suspend our disbelief for a while and to just enjoy the ride. Maybe there could be a pathogen capable of doing it? Well, there are a variety of real-world diseases that can alter human behavior. From rabies to prions, and some of them can cause aggression, confusion, and even paralysis. Although none of these can actually bring the dead back to life, they show that our brains are complex and vulnerable to external influences. Then there’s the question of how the zombie outbreak would spread. Most zombie scenarios involve some kind of rapid transmission. That could be through bites, scratches, or even airborne pathogens. In reality, a disease that spreads so quickly and effectively would be a major threat. And if a zombie pandemic were to happen, how would we deal with it? It’s a grim thought, but most zombie movies depict a society struggling to cope. Infrastructure collapses, communication breaks down, and people are forced to fight for survival. Governments would likely try to contain the outbreak, through quarantine, military intervention, and other measures. It’s definitely a scary thought, but by thinking about these scenarios, we can better prepare for any kind of crisis. Even though zombies aren’t real, the principles of disaster preparedness apply to many different situations.
Zombie Survival Tips: How to Prepare for the Apocalypse
Alright, let’s get practical, guys. Just in case the unthinkable happens, here’s some essential zombie survival advice. Look, let’s be realistic: we can’t completely prepare for everything. But we can take steps to increase our chances of survival. Knowing how to deal with an zombie outbreak is key to surviving. One of the first things you need is a safe place. Ideally, it should be defensible, with limited access points and a good view of the surrounding area. Think of a secure location such as a fortified house, a remote cabin, or even a well-stocked bunker. Stock up on supplies: food, water, first-aid kits, and communication devices. Consider having non-perishable food, water purification tablets, and a reliable way to contact the outside world. This can be the difference between life and death during a zombie apocalypse . If you’re a beginner, start with the basics. Think about how to secure your home. Board up windows, reinforce doors, and create barriers to slow down the undead . Then, consider what you would do to defend yourself. Weapons, whether they are melee weapons like a baseball bat or firearms, are crucial in a zombie situation. Practice with them, and know how to use them effectively. Remember that silence is often your best friend. Zombies are often drawn to noise, so try to move quietly and avoid unnecessary sounds. This is very important when you are trying to stay away from the walking dead . Teamwork makes the dream work! Surround yourself with reliable people. This is true for life in general, but it is especially true in a crisis. Find allies, and work together. This will increase your chance of survival. And finally, stay informed. If a zombie outbreak were to occur, you would need to know what to do and what not to do. Keep an eye on local news, and follow any instructions issued by authorities. But remember to stay calm. Panic can be your worst enemy in a survival situation. Focus on the basics, and try to make rational decisions.
Essential Survival Kit Checklist
Here’s a basic list to get you started.
- Food and Water: Non-perishable items, water bottles, and water purification tablets.
- First-Aid: Bandages, antiseptic, pain relievers, and any personal medication.
- Weapons: Baseball bat, hatchet, or firearms (if you’re trained and licensed).
- Communication: A two-way radio or a cell phone.
- Navigation: A map and a compass.
- Shelter: A sturdy shelter, such as your house.
- Clothing: Durable clothing, including a jacket and sturdy boots.
- Tools: A multi-tool, duct tape, and a flashlight.
The Future of Zombies: What’s Next?
So, what’s next for the zombie genre ? Where do we go from here? The beauty of zombies is their capacity for adaptation. Expect more movies, games, and TV shows to continue exploring the theme of the undead . They will push the boundaries of the zombie apocalypse in new and exciting ways. And we can expect to see the evolution of the genre continuing. Writers, directors, and game developers will be looking for new and original takes on the zombie narrative. Maybe we’ll see more stories about zombies with a social conscience. Maybe we’ll see a shift toward more scientific and realistic approaches. Or maybe we’ll get more tales about the zombie outbreak , told from the perspective of the zombies themselves. The possibilities are truly endless. The zombie genre is not going anywhere. It will continue to captivate, challenge, and terrify audiences for many years to come. So keep an eye out for the latest zombie news . Get ready to run, hide, and maybe even fight the undead . And remember: stay safe out there, guys!